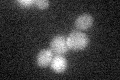
YHR133C
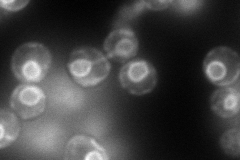
YHR133C
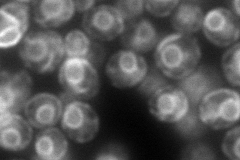
YHR133C
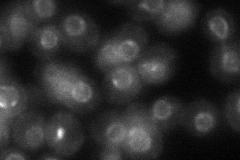
YHR133C
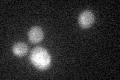
YHR133C

View description
Protein involved in regulation of sterol biosynthesis; specifically stabilizes Hmg2p, one of two HMG-CoA isoenzymes that catalyze the rate-limiting step in sterol biosynthesis; homolog of mammalian INSIG proteins
Localization:
Intensity:
Fold change:
Significance:
-
C’ GFP library in SD
below threshold14.03 -
N' NOP1pr-GFP in SD
ER188.43 -
N' TEF2pr-mCherry in SD
ER193.146 -
N' NATIVEpr-GFP in SD
cell periphery,punctate50.8049 -
N' TEF2pr-VC and Cyto-VN in SD

ER51.7944 -
C’ GFP library in SD+DTT
cytosol13.890.98No -
C’ GFP library in SD+H2O2

cytosol15.551.1No -
C’ GFP library in Starvation Media

cytosol15.251.08No -
C’ GFP library on the background of Pup2-DaMP

N/A -
C’ GFP library on the background of CCT mutant

N/A0N/AYes
